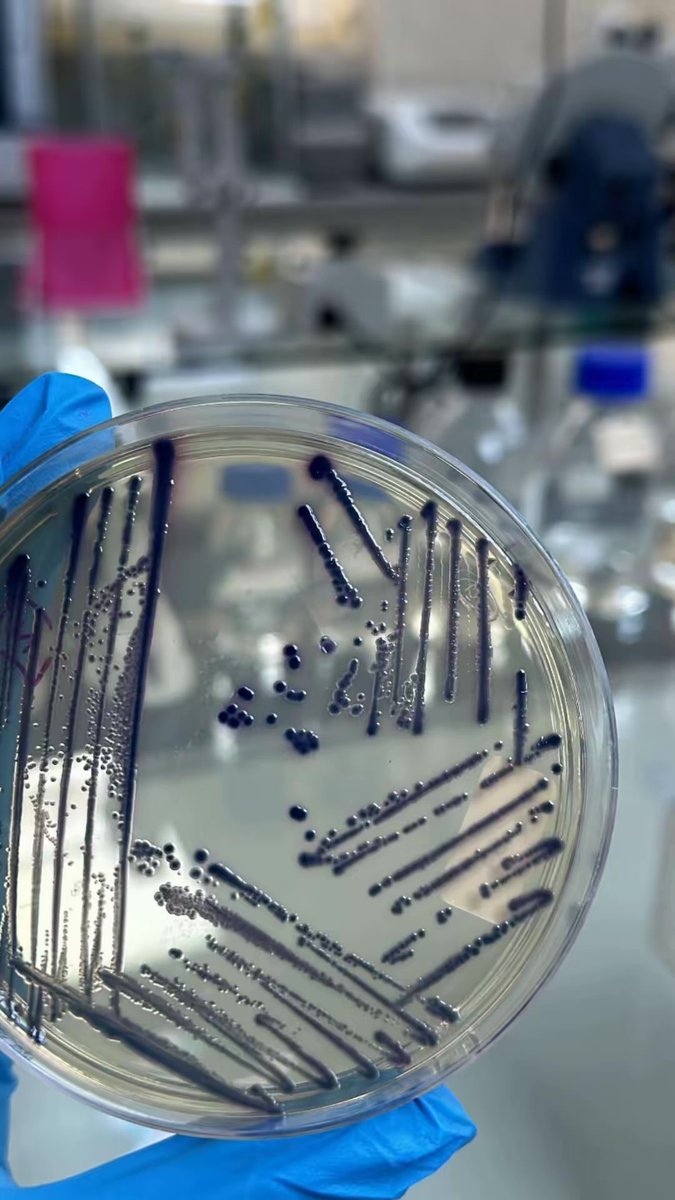
Salha Alshehri💫 tweet media

Salha Alshehri💫
64 posts

Salha Alshehri💫 retweetledi

شكرًا للدكتور على حديثه الملهم اللي فتح لنا نظره أوسع عن فرص كليات العلوم ومساراتها المستقبلية. ✨
@Dr_Fayez_sh

العربية

من 2018 وأنا أحلم بقبول من كاوست،
واليوم بداية تحقيق الحلم 🤍
بسم الله وعلى بركة الله نبدأ نتعمق بأكثر مجال احبه 👩🏻💻
كاوست، استعدي لاستقبال أصايل بنسخة المعلوماتية الحيوية 🧬✨

KAUST Academy@KAUST_Academy
🎉 تهانينا للطلاب المقبولين! تعلن أكاديمية كاوست أن جميع الطلاب المقبولين في البرامج التالية قد تم إرسال دعوات كورسيرا لهم: ✅ الذكاء الاصطناعي ✅ المعلوماتية الحيوية ✅ استدامة المياه ✅ الطاقة المتجددة 📧 يرجى التحقق من بريدكم الإلكتروني لاستكمال التسجيل والبدء في رحلتكم التعليمية! هل أنتم مستعدون لتطوير مهاراتكم وصناعة المستقبل؟ 🇸🇦 📍الأمن السيبراني - قريباً📍 #KAUST_Academy #KAUST #SaudiTalent #AI #Bioinformatics #WaterSustainability #RenewableEnergy #Cybersecurity
العربية

@Dr_Fayez_sh ما شاء الله تبارك الله مبروك دكتور
الله ينفع بها 👏
العربية

بعد فضل الله وتوفيقه 🤍
وبعد سنواتٍ من البحث والتجارب والسهر والتحديات…
أصبحتُ رسميًا د. وِد م. الرشيدي
دكتوراه في الوراثة والبيولوجيا الجزيئية، عن بحثي في هندسة الطحالب البحرية الدقيقة لتوليد الطاقة الحيوية المستدامة ⚡🌊
الحمد لله دائمًا وأبدًا، ولكل من دعمني وآمن بي
#PhD



العربية
Salha Alshehri💫 retweetledi

تنظم كلية علوم الحاسب بـ #جامعة_الملك_خالد اللقاء التعريفي ببرامج @KAUST_NewsAR، بهدف تعريف الطلاب بفرص التدريب والتطوير التي تقدمها #كاوست، وتمكينهم من تنمية مهاراتهم واكتساب خبرات بحثية وعلمية نوعية..

العربية

@iaf_naan ما شاء الله تبارك الله أفنان ،من أطيب وأجمل الناس اللي تشرفت فيهم كنتِ خير مثال في العطاء والتعاون وأسأل الله يحقق لك مبتغاك 💗💗✨
العربية

@loptt09 @Dr_Fayez_sh شفت فرص تدريب كثيرة في الرياض سواء في أمانة الرياض أو المراكز البحثية حاول تبحث في لينكدإن.
وبالنسبة لتدريب الهيئة الغذاء و الدواء لو حاب تدريب تمهير فهم يعلنون عن الفرص في حساباتهم، وقبل فترة كانوا منزلين فرص
العربية

@S_aa2001 @Dr_Fayez_sh كيف احصل على مثل هذا التدريب او دورات عمليه في الرياض؟
العربية

الحمد لله خلصت ألطف فترة تدريب 💗💗💗👩🔬✨
كانت تجربة ثرية ومليئة بالتعلم، أشياء كثير كان ودي أطبقها من أيام الجامعة واشياء كثير تعلمتها
ممتنة للدكتور @Dr_Fayez_sh لتوجيهك ودعمك 🙏🏻
#تدريب
#تجربة_مهنية
#فرص_تطوير
#التقنية_الحيوية
#الميكروبيولوجي

العربية


















